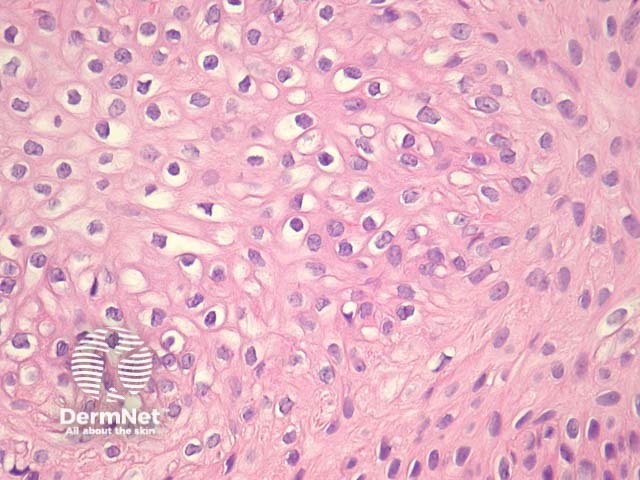
Figure 6

Main menu
Common skin conditions
NEWS
Join DermNet PRO
Read more
Quick links
Author: Dr Ben Tallon, Dermatologist/Dermatopathologist, Tauranga, New Zealand, 2010; Assoc Prof Patrick Emanuel, Dermatopathologist, Auckland, New Zealand, 2014.
Pilar sheath acanthoma usually involves the skin of the upper lip and presents as a small papule with a central pore.
In pilar sheath acanthoma, there is a lobular proliferation of benign squamous epithelium in the dermis (figure 1, 2). These lobules surround small cystic spaces. The lining cells may have a granular layer similar to an epidermoid cyst (figure 3) or have an attenuated granular layer similar to a trichilemmal cyst (figure 4).
The lobules are composed of bland keratinocytes and are surrounded in areas by an eosinophilic basement membrane. There are often areas of clear cells (figures 5, 6). These features indicate outer root sheath differentiation.

Figure 1

Figure 2

Figure 3

Figure 4

Figure 5
Figure 6
Dilated pore of Winer: These contain a larger cystic space which is surrounded by radiating thin strands of epithelium as opposed to the lobular arrangement of pilar sheath acanthoma
Trichofolliculoma: radiating hair follicles in variable states of maturity are seen to extend from the central dilated pore or cystic structure.